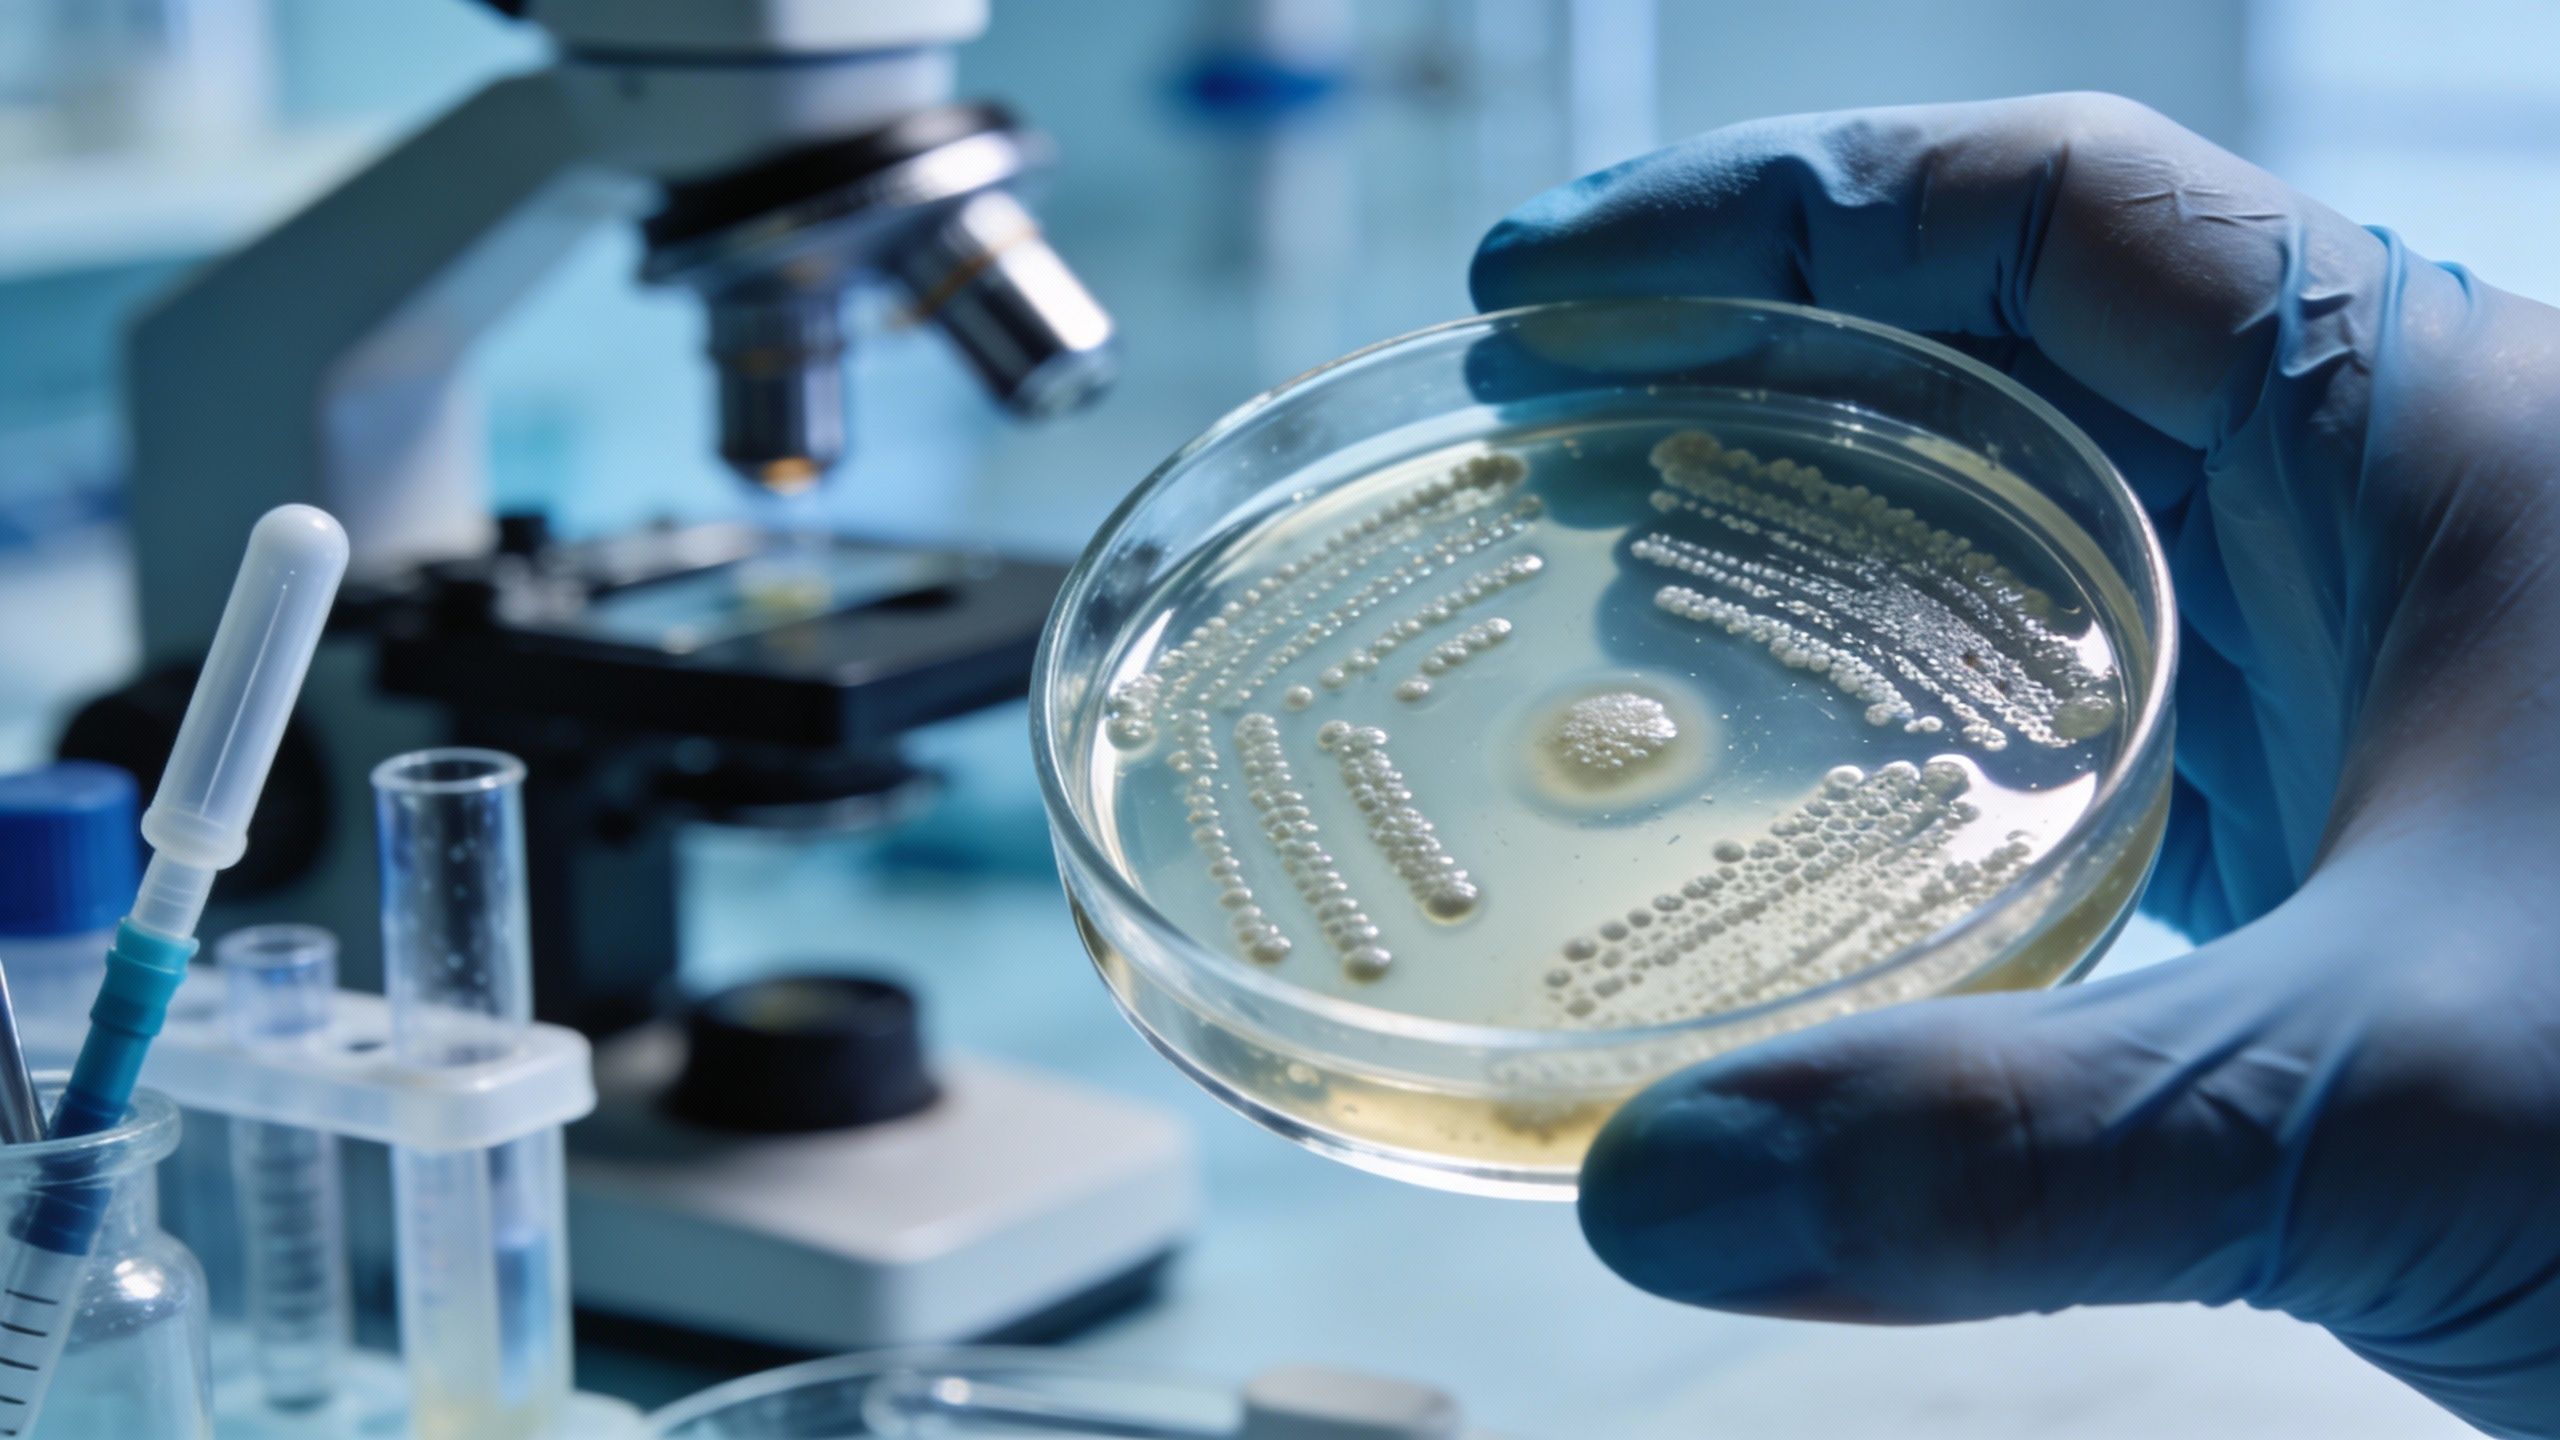

Pollution de l’air : ce lien invisible entre vos poumons, votre ventre et votre cœur
Auteur: Mathieu Gagnon
Une menace silencieuse qui dépasse nos poumons

On sait tous, plus ou moins, que respirer un air pollué est mauvais pour la santé. C’est le genre de vérité qu’on accepte sans trop y penser, n’est-ce pas ? Pourtant, une étude récente vient de mettre en lumière des détails bien plus spécifiques — et franchement, un peu inquiétants — montrant que la pollution de l’air pourrait endommager simultanément notre intestin et notre cœur.
Ce n’est pas de la science-fiction. Des scientifiques ont réussi à identifier la source de la plaque artérielle humaine en traçant un chemin pour le moins inattendu : un parcours débutant dans les voies respiratoires, passant par les bactéries intestinales, pour finir sa course dans le cœur.
C’est à l’Université de Californie, à Los Angeles (UCLA), qu’une équipe s’est penchée sur ce mécanisme avec une précision chirurgicale. Les travaux ont été dirigés par le Dr Jesus A. Araujo, docteur en médecine et en philosophie, dont les recherches se concentrent spécifiquement sur la cardiologie environnementale et la prévention. Ce qu’ils ont découvert change un peu la donne sur notre façon de voir la pollution.
Le voyage toxique : des voies respiratoires à l’intestin
Vous vous demandez sûrement comment de la fumée ou des particules dans l’air peuvent atterrir dans votre système digestif. Le processus est plus mécanique qu’on ne le pense. Le mucus présent dans les voies respiratoires de notre corps piège les envahisseurs étrangers et les particules trouvées dans l’air sale. Ensuite, les poumons déplacent ces particules vers le haut, en direction de la gorge.
C’est là que ça se joue : l’acte d’avaler déplace ensuite ce matériel directement dans le tube digestif et la paroi intestinale. Comme les particules ultrafines sont… eh bien, minuscules, certaines d’entre elles migrent de la paroi intestinale vers la circulation sanguine, pour finalement traverser le cœur. C’est un cycle infernal.
Pour prouver cela, les chercheurs de l’UCLA ont mené une expérience sur des souris, comparant des animaux respirant un air pollué à d’autres respirant un air filtré sur une période de 10 semaines. Le protocole était strict : chaque groupe passait 6 heures par jour, 3 jours par semaine, dans l’air qui lui était assigné, et des échantillons intestinaux ont été suivis de près.
Les résultats ? L’air pollué a modifié le mélange de microbes dans le caecum — qui est la première poche du gros intestin — mais curieusement, pas dans l’intestin grêle. Pourquoi est-ce important ? Parce que cette zone gère la fermentation. Des changements à cet endroit peuvent littéralement réécrire la chimie bactérienne avant même qu’elle n’atteigne le foie et les vaisseaux sanguins.
Stress chimique et confusion bactérienne

Ce qui est fascinant, et un peu complexe, c’est qu’il n’y a pas un seul coupable bactérien. Selon une revue des données, les microbes intestinaux transforment la nourriture en produits chimiques qui atteignent d’autres organes. Dans cette étude précise, l’équipe n’a pas jeté la pierre à une espèce unique, se concentrant plutôt sur les changements au niveau de la communauté microbienne globale.
Les tests fécaux ont également montré des niveaux plus élevés d’acides gras à chaîne courte, qui sont de petites molécules fabriquées lorsque les microbes fermentent les fibres. Ces changements chimiques combinés pourraient compter bien plus que n’importe quel microbe isolé, même si les chercheurs doivent encore prouver le lien de cause à effet direct.
Au-delà de l’intestin, les souris exposées ont montré des signes que leur foie subissait une pression chimique après des semaines à respirer la pollution. Les cellules hépatiques ont même activé des gènes protecteurs en réponse au stress oxydatif. Le même tissu a montré une tension dans le repliement des protéines, ce qui signifie, en gros, que les cellules du foie avaient du mal à assembler de nouvelles protéines proprement et à maintenir un métabolisme stable. L’étude n’a pas montré quels signaux du foie atteignaient les artères, donc le lien hépatique nécessite encore une preuve directe, mais les indices sont là.
Plaque, génétique et risques invisibles

Les conséquences sont réelles. Les chercheurs ont observé une athérosclérose aggravée chez les souris exposées à la pollution après l’essai. Un autre article a lié l’exposition aux particules à des signaux de coagulation plus forts à l’intérieur des artères, un changement qui peut nourrir la croissance de la plaque.
« Cependant, les mécanismes et les voies spécifiques par lesquels cela se produit restent largement inconnus », admet le Dr Araujo. Il faut noter que ces souris ont été élevées pour former de la plaque facilement, donc les résultats ne peuvent pas prédire exactement à quelle vitesse la même chaîne se joue chez les humains.
Un détail troublant a émergé : l’intestin ne montrait aucune inflammation évidente pendant l’exposition. C’est effrayant car cela rend les dommages internes faciles à manquer. Des changements de bas grade peuvent agir sous le radar, car des bactéries altérées peuvent laisser fuir des molécules dans le sang sans causer de douleur. Le Dr Araujo prévient : « J’aimerais qu’ils soient conscients que la pollution de l’air favorise les maladies cardiovasculaires et augmente les décès cardiovasculaires via des mécanismes… encore à déterminer. En conséquence, la pollution de l’air pourrait dévaster la vie des gens silencieusement et sans aucun avertissement. »
Enfin, parlons génétique. L’exposition est partagée, pourtant nos corps répondent différemment. Les gènes peuvent influencer quels microbes s’installent tôt dans la vie. « Bien que tout le monde soit exposé à des niveaux similaires de pollution de l’air dans un certain endroit, la santé de tout le monde n’est pas affectée au même degré », précise Araujo.
Conclusion : Un enjeu de santé publique mondial

Pour mettre tout cela en perspective, l’Organisation mondiale de la santé (OMS) a estimé à 4,2 millions le nombre de décès prématurés dus à la pollution de l’air extérieur en 2019. Le même rapport indiquait que 68 % de ces décès provenaient de maladies cardiaques et d’accidents vasculaires cérébraux, ce qui montre à quel point le risque est étendu.
Bien sûr, les gens peuvent réduire l’exposition avec une filtration intérieure et des masques bien ajustés les jours de mauvais air, mais soyons réalistes : ces outils dépendent de l’argent et du temps. Des rues plus propres, une énergie plus propre et des contrôles industriels plus stricts protègent tout le monde à la fois, ce qui est le but de la politique publique.
Prises ensemble, les découvertes de l’UCLA, publiées dans Environment International, ont lié la pollution inhalée aux changements de la communauté intestinale, à la tension hépatique et à la formation plus rapide de plaque chez les souris vulnérables. Les travaux futurs testeront si changer les bactéries intestinales ou bloquer leurs produits chimiques peut ralentir la plaque. D’ici là, on ne regardera plus l’air de la même façon.
Selon la source : earth.com
Créé par des humains, assisté par IA.